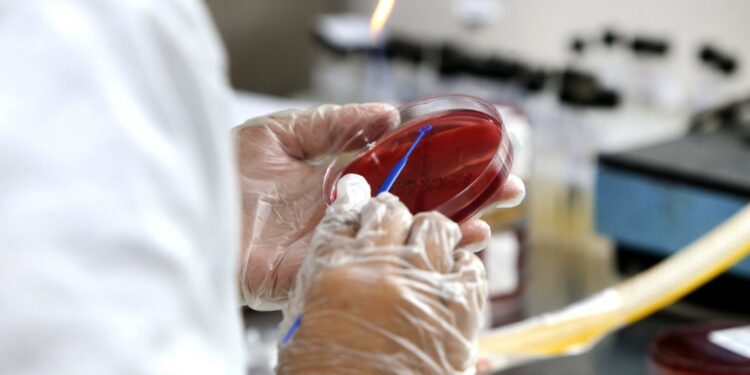
Infectologistas projetam predomínio da delta entre outubro e novembro em Salvador

A variante delta da Covid-19 está agravando a situação da pandemia em diversos países do mundo e já chegou ao Brasil. No Rio de Janeiro, a cepa, surgida inicialmente na Índia, vem provocando um aumento de casos da doença, o que poderia significar uma possível nova onda de contágio.
Por outro lado, Salvador vem registrando indicadores do coronavírus cada vez mais baixos, indicando uma possível melhora da crise sanitária na capital.
Infectologistas , alertam para um aumento dos casos nos próximos meses, devido à rápida propagação da nova mutação do vírus.“A minha expectativa é de que a gente venha a ter um aumento no número de casos nos próximos meses, em torno de outubro a novembro, porque a gente tem visto isso em outros locais. Eu não tenho porque acreditar que aqui em Salvador, na Bahia, vai ser diferente”, avalia o médico Gleuber Sousa.
A especialista Clarissa Cerqueira partilha da mesma percepção e ainda acrescenta que há a chance da variante delta já estar em circulação na cidade. “Há uma grande possibilidade da variante estar circulando aqui [Salvador] porque no Rio de Janeiro está propagando muito já e as pessoas se locomovem entre os estados. Na Bahia, é mais provável que a gente não tenha identificado os casos”, diz.
No entanto, Robson Reis, infectologista, acredita que, mesmo com o cenário epidemiológico do Rio de Janeiro, ainda não é possível estimar quando a variante delta causará um impacto em Salvador. “Não tem como ter previsão. O Brasil é um país de dimensão continental, é difícil fazer uma projeção”, observa.
Ppr Kris Couto